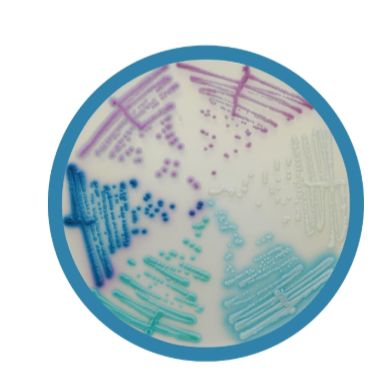
Chromagar法国科玛嘉 显色培养基,增补剂,预制平板,选择性培养基

相关产品推荐更多 >
万千商家帮你免费找货
0 人在求购买到急需产品
- 详细信息
- 技术资料
- 库存:
99
- 现货状态:
现货
- 供应商:
北京云肽生物科技有限公司
Chromagar法国科玛嘉 显色培养基,增补剂,预制平板,选择性培养基
厂家:Chromagar
产品:微生物干粉培养基,添加剂,预制培养基
用途:微生物的选择性培养
产地:法国
法国Chromagar科玛嘉微生物公司在1993年由 Alain Rambach 成立, 他也是科玛嘉显色培养基的开拓者。成立于法国的中心——巴黎,离著名的巴斯德研究所不远的地方,RAMBACH博士开始了他的研究生涯,玛嘉提供创新的显色培养基的解决方案,旨在改善和简化传统的培养技术。
Chromagar显色培养基和增补剂
产品列表:
|
货号 |
产品名称 |
用途 |
包装规格 |
|
SA130 |
沙门氏菌显色培养基 |
用于沙门氏菌的检测和分离(伤寒沙门氏jun和甲型副伤寒沙门氏jun) |
1L |
|
SA133-25 |
25L | ||
|
SA162-1 |
沙门氏+显色培养基(含增补剂1&增补剂2) |
用于沙门氏菌(伤寒沙门氏jun和乳糖阳性沙门氏菌)的分离和检测(依据ISO 6579:2002标准) |
1L |
|
SA162 |
5L | ||
|
SQ001 |
快速检测沙门氏菌液体培养基 |
用于沙门氏菌的分离和检测 |
1L |
|
RR702-1 |
RambachTM Agar显色培养基(含增补剂) |
用于食品中沙门氏菌的分离和检测 |
1L |
|
RR702 |
5L | ||
|
SA130-s |
改良沙门选择性添加剂 |
用于沙门氏菌属的分离和检测 |
1L |
|
TA670 |
金黄色葡萄球jun显色培养基 |
用于金黄色葡萄球jun的分离和鉴别 |
1L |
|
TA672 |
5L | ||
|
MR500(B) |
MRSA显色培养基(含增补剂) |
用于耐甲氧西林金黄色葡萄球jun(MRSA)的分离和鉴别 |
1L |
|
MR502 |
5L | ||
|
CQ382-1 |
葡萄球菌显色培养基 |
用于葡萄球菌属的检测和分离 |
1L |
|
CQ382 |
5L | ||
|
CQ392-1 |
链球菌显色培养基(含增补剂) |
用于链球菌属的分离和鉴别 |
1L |
|
CQ392 |
5L | ||
|
LM851 |
李斯特菌显色培养基(含增补剂) |
用于单核细胞增生李斯特菌的检测、分离和计数 |
1L |
|
LM852 |
5L | ||
|
LM851(S) |
李斯特菌显色培养基增补剂 |
与LM851配套使用 |
1L |
|
LK970 |
鉴定李斯特菌显色培养基(含增补剂) |
用于单核细胞增生李斯特菌的进一步鉴别 |
250ml |
|
VB910 |
弧菌显色培养基 |
用于副溶血弧菌,创伤弧菌和霍乱弧jun的分离和检测 |
1L |
|
VB912 |
5L | ||
|
VB910-s |
改良弧菌选择性添加剂 |
与VB910配套使用 |
1L |
|
EC166 |
大肠杆菌显色培养基 |
用于食品和水样中的β-葡萄糖醛酸苷酶阳性大肠杆菌的分离和计数 |
1L |
|
EC169-25 |
25L | ||
|
EE220 |
O157显色培养基 |
用于临床和食品中大肠杆菌O157的检测 |
1L |
|
EE223-25 |
25L | ||
|
EE220-s |
改良O157选择性添加剂 |
与EE220配套使用 |
1L |
|
ST160 |
STEC显色培养基(含增补剂) |
用于产志贺毒素大肠杆菌(STEC)的检测 |
1L |
|
ST162 |
5L | ||
|
EF342-1 |
CCA显色培养基 |
用于菌体含量较低的水样中β-葡萄糖醛酸苷酶阳性大肠杆菌和大肠菌群的检测和计数(依据ISO9308-1标准) |
1L |
|
EF342 |
5L | ||
|
TX182-1 |
TBX显色培养基 |
用于食品和动物饲料中β-葡萄糖醛酸苷酶阳性大肠杆菌的检测和计数(依据ISO16649标准) |
1L |
|
TX182 |
5L | ||
|
SC172-1 |
mSuperCARBATM显色培养基(含增补剂1&增补剂2) |
用于产碳青霉烯酶的肠杆菌科(CRE)的检测和分离 |
1L |
|
SC172 |
5L | ||
|
KPRT2-1 |
KPC显色培养基(含增补剂) |
用于碳青霉类敏感型革兰氏阴性菌的检测 |
1L |
|
KPRT2 |
5L | ||
|
ESRT2-1 |
ESBL显色培养基(含增补剂) |
用于超广谱β-内酰胺酶革兰氏阴性菌(ESBL)的隔夜检测 |
1L |
|
ESRT2 |
5L | ||
|
VR952-1 |
VRE显色培养基(含增补剂) |
用于抗万古霉素肠球菌(VRE)的检测 |
1L |
|
VR952 |
5L | ||
|
EF320 |
ECC显色培养基 |
用于食品和水样中β-葡萄糖醛酸苷酶阳性大肠杆菌和大肠菌群的检测和计数 |
1L |
|
EF323-25 |
25L | ||
|
AQ056-1 |
液体ECC(定性)显色培养基 |
用于水样中大肠杆菌和大肠菌群的检测 |
1L |
|
AQ056 |
5L | ||
|
EL382-1 |
液体ECC(定量)显色培养基 |
用于水样中大肠杆菌和大肠菌群的检测和计数 |
1L |
|
EL382 |
5L | ||
|
CA220 |
念珠菌显色培养基 |
用于念珠菌的检测 |
1L |
|
CA223-25 |
25L | ||
|
RT410 |
尿路菌群定位显色培养基 |
用于尿道菌群的分离和鉴别 |
1L |
|
RT413-25 |
25L | ||
|
MH482-1 |
MH尿路菌群定位显色培养基(含增补剂) |
用于抗生素敏感型尿道菌群的鉴别 |
1L |
|
MH482 |
5L | ||
|
BC732-1 |
蜡样芽胞杆菌显色培养基(含增补剂) |
用于环境和食品中蜡样芽胞杆菌的检测和计数 |
1L |
|
BC732 |
5L | ||
|
CS812 |
阪崎肠杆菌显色培养基 |
用于奶制品中阪崎肠杆菌的检测 |
1L |
|
ESM012T |
志贺氏菌显色培养基 |
用于志贺氏菌的选择性分离 |
1L |
|
PS830 |
假单胞菌属显色培养基 |
用于假单胞菌的检测和分离 |
1L |
|
PS832 |
5L | ||
|
SB282-1 |
B族链球菌显色培养基(含增补剂1&增补剂2) |
用于B群链球菌的分离和鉴别 |
1L |
|
SB282 |
5L | ||
|
YE492-1 |
小肠结肠炎耶尔森氏菌显色培养基(含增补剂) |
用于小肠结肠炎耶尔森氏菌的检测和直接鉴别 |
1L |
|
YE492 |
5L | ||
|
MZ282-1 |
马拉色显色培养基 |
用于马拉色菌的检测 |
1L |
|
MZ282 |
5L | ||
|
AC092-1 |
不动杆菌显色培养基(含增补剂) |
用于不动杆菌和泛耐药(MDR)不动杆菌的检测 |
1L |
|
AC092 |
5L | ||
|
CP572-1 |
弯曲菌显色培养基(含增补剂) |
用于耐热型弯曲菌的检测、鉴别和计数 |
1L |
|
CP572 |
5L | ||
|
CD122-1 |
艰难梭状芽胞杆菌显色培养基(含增补剂) |
用于艰难梭状芽胞杆菌的检测 |
1L |
|
CD122 |
5L | ||
|
MS252/P-1 |
乳腺炎革兰氏阳性菌显色培养基(含增补剂) |
用于乳腺炎革兰氏阳性致病菌的分离和检测 |
1L |
|
MS252/P |
5L | ||
|
MS252/N-1 |
乳腺炎革兰氏阴性菌显色培养基 |
用于乳腺炎革兰氏阴性致病菌的分离和检测 |
1L |
|
MS252/N |
5L | ||
|
PF652-1 |
产气荚膜梭菌显色培养基(含增补剂1&增补剂2) |
用于产气荚膜梭菌的检测、分离和计数 |
1L |
|
PF652 |
5L | ||
|
CO262-1 |
COL-APSE 显色培养基(含增补剂) |
用于耐多粘菌素型革兰氏阴性菌的检测和分离 |
1L |
|
CO262 |
5L | ||
|
CA243-1 |
念珠+显色培养基 |
用于念珠菌(包含耳念珠菌)的分离和检测 |
1L |
|
CA243-25 |
25L | ||
|
SM302-1 |
粘质沙雷氏jun显色培养基(含增补剂) |
用于粘质沙雷氏的分离和检测 |
1L |
|
SM302 |
5L | ||
|
SP372-1 |
A族链球菌显色培养基(含增补剂1&增补剂2) |
用于A族链球菌的分离和检测 |
1L |
|
SP372 |
5L | ||
|
CGRT2-1 |
C3G显色培养基(含增补剂) |
用于产β-内酰胺酶革兰氏阴性菌(含ESBL和AmpC型)的检测 |
1L |
|
CGRT2 |
5L | ||
|
EB042-1 |
肠杆菌科细菌显色培养基(含增补剂1&增补剂2) |
用于肠杆菌科细菌的分离和检测 |
1L |
|
EB042 |
5L |
Chromagar显色培养基预制培养基
产品列表:
|
货号 |
产品名称 |
平板直径 |
包装规格 |
|
AC092P-70 |
科玛嘉不动杆菌显色平板 |
70mm |
10个/包,2包/盒 |
|
AC092P-90 |
科玛嘉不动杆菌显色平板 |
90mm |
10个/包,2包/盒 |
|
AC092PS-70 |
科玛嘉不动杆菌显色平板(MDR) |
70mm |
10个/包,2包/盒 |
|
AC092PS-90 |
科玛嘉不动杆菌显色平板(MDR) |
90mm |
10个/包,2包/盒 |
|
BC732P-70 |
科玛嘉蜡样芽胞杆菌显色平板 |
70mm |
10个/包,2包/盒 |
|
BC732P-90 |
科玛嘉蜡样芽胞杆菌显色平板 |
90mm |
10个/包,2包/盒 |
|
CA220P-70 |
科玛嘉念珠菌显色平板 |
70mm |
10个/包,2包/盒 |
|
CA220P-90 |
科玛嘉念珠菌显色平板 |
90mm |
10个/包,2包/盒 |
|
CD122P-70 |
科玛嘉艰难梭状芽孢杆菌显色平板 |
70mm |
10个/包,2包/盒 |
|
CD122P-90 |
科玛嘉艰难梭状芽孢杆菌显色平板 |
90mm |
10个/包,2包/盒 |
|
CP572P-70 |
科玛嘉弯曲菌显色培养基平板 |
70mm |
10个/包,2包/盒 |
|
CP572P-90 |
科玛嘉弯曲菌显色培养基平板 |
90mm |
10个/包,2包/盒 |
|
CS812P-70 |
科玛嘉阪崎肠杆菌显色平板 |
70mm |
10个/包,2包/盒 |
|
CS812P-90 |
科玛嘉阪崎肠杆菌显色平板 |
90mm |
10个/包,2包/盒 |
|
EC166P-70 |
科玛嘉大肠杆菌显色平板 |
70mm |
10个/包,2包/盒 |
|
EC166P-90 |
科玛嘉大肠杆菌显色平板 |
90mm |
10个/包,2包/盒 |
|
EE220P-70 |
科玛嘉大肠杆菌O157显色平板 |
70mm |
10个/包,2包/盒 |
|
EE220P-90 |
科玛嘉大肠杆菌O157显色平板 |
90mm |
10个/包,2包/盒 |
|
EE220sP-70 |
科玛嘉改良大肠杆菌O157显色平板 |
70mm |
10个/包,2包/盒 |
|
EE220sP-90 |
科玛嘉改良大肠杆菌O157显色平板 |
90mm |
10个/包,2包/盒 |
|
EF320P-70 |
科玛嘉ECC显色平板 |
70mm |
10个/包,2包/盒 |
|
EF320P-90 |
科玛嘉ECC显色平板 |
90mm |
10个/包,2包/盒 |
|
ESM012TP-70 |
科玛嘉志贺氏菌显色平板 |
70mm |
10个/包,2包/盒 |
|
ESM012TP-90 |
科玛嘉志贺氏菌显色平板 |
90mm |
10个/包,2包/盒 |
|
ESRT2P-70 |
科玛嘉ESBL显色平板 |
70mm |
10个/包,2包/盒 |
|
ESRT2P-90 |
科玛嘉ESBL显色平板 |
90mm |
10个/包,2包/盒 |
|
KPRT2P-70 |
科玛嘉KPC显色平板 |
70mm |
10个/包,2包/盒 |
|
KPRT2P-90 |
科玛嘉KPC显色平板 |
90mm |
10个/包,2包/盒 |
|
LM851P-70 |
科玛嘉李斯特菌显色平板 |
70mm |
10个/包,2包/盒 |
|
LM851P-90 |
科玛嘉李斯特菌显色平板 |
90mm |
10个/包,2包/盒 |
|
MR500P-70 |
科玛嘉MRSA显色平板 |
70mm |
10个/包,2包/盒 |
|
MR500P-90 |
科玛嘉MRSA显色平板 |
90mm |
10个/包,2包/盒 |
|
MS252/N-70 |
乳腺炎革兰氏阴性菌显色平板 |
70mm |
10个/包,2包/盒 |
|
MS252/N-90 |
乳腺炎革兰氏阴性菌显色平板 |
90mm |
10个/包,2包/盒 |
|
MS252/P-70 |
乳腺炎革兰氏阳性菌显色平板 |
70mm |
10个/包,2包/盒 |
|
MS252/P-90 |
乳腺炎革兰氏阳性菌显色平板 |
90mm |
10个/包,2包/盒 |
|
MS252D-90 |
乳腺炎革兰氏菌显色平板(阴性&阳性) |
90mm |
10个/包,2包/盒 |
|
MZ282P-70 |
科玛嘉马拉色菌显色平板 |
70mm |
10个/包,2包/盒 |
|
MZ282P-90 |
科玛嘉马拉色菌显色平板 |
90mm |
10个/包,2包/盒 |
|
PF652-70 |
科玛嘉产气荚膜梭菌显色平板 |
70mm |
10个/包,2包/盒 |
|
PF652-90 |
科玛嘉产气荚膜梭菌显色平板 |
90mm |
10个/包,2包/盒 |
|
PS830P-70 |
科玛嘉假单胞菌显色平板 |
70mm |
10个/包,2包/盒 |
|
PS830P-90 |
科玛嘉假单胞菌显色平板 |
90mm |
10个/包,2包/盒 |
|
RT410P-70 |
科玛嘉尿路菌群定位显色平板 |
70mm |
10个/包,2包/盒 |
|
RT410P-90 |
科玛嘉尿路菌群定位显色平板 |
90mm |
10个/包,2包/盒 |
|
SA130P-70 |
科玛嘉沙门氏菌显色平板 |
70mm |
10个/包,2包/盒 |
|
SA130P-90 |
科玛嘉沙门氏菌显色平板 |
90mm |
10个/包,2包/盒 |
|
SA130SP-70 |
科玛嘉改良沙门氏菌显色平板 |
70mm |
10个/包,2包/盒 |
|
SA130SP-90 |
科玛嘉改良沙门氏菌显色平板 |
90mm |
10个/包,2包/盒 |
|
SA162P-70 |
科玛嘉沙门氏+显色平板 |
70mm |
10个/包,2包/盒 |
|
SA162P-90 |
科玛嘉沙门氏+显色平板 |
90mm |
10个/包,2包/盒 |
|
SB282P-70 |
科玛嘉B群链球菌显色平板 |
70mm |
10个/包,2包/盒 |
|
SB282P-90 |
科玛嘉B群链球菌显色平板 |
90mm |
10个/包,2包/盒 |
|
SC172P-70 |
科玛嘉mSuper CARBA显色平板 |
70mm |
10个/包,2包/盒 |
|
SC172P-90 |
科玛嘉mSuper CARBA显色平板 |
90mm |
10个/包,2包/盒 |
|
ST160P-70 |
科玛嘉STEC显色平板 |
70mm |
10个/包,2包/盒 |
|
ST160P-90 |
科玛嘉STEC显色平板 |
90mm |
10个/包,2包/盒 |
|
TA670P-70 |
科玛嘉金黄色葡萄球jun显色平板 |
70mm |
10个/包,2包/盒 |
|
TA670P-90 |
科玛嘉金黄色葡萄球jun显色平板 |
90mm |
10个/包,2包/盒 |
|
VB910P-70 |
科玛嘉弧菌显色平板 |
70mm |
10个/包,2包/盒 |
|
VB910P-90 |
科玛嘉弧菌显色平板 |
90mm |
10个/包,2包/盒 |
|
VB910sP-70 |
科玛嘉改良弧菌显色平板 |
70mm |
10个/包,2包/盒 |
|
VB910sP-90 |
科玛嘉改良弧菌显色平板 |
90mm |
10个/包,2包/盒 |
|
VR952P-70 |
科玛嘉VRE显色平板 |
70mm |
10个/包,2包/盒 |
|
VR952P-90 |
科玛嘉VRE显色平板 |
90mm |
10个/包,2包/盒 |
|
YE492P-70 |
科玛嘉小肠结肠炎耶尔森氏菌显色平板 |
70mm |
10个/包,2包/盒 |
|
YE492P-90 |
科玛嘉小肠结肠炎耶尔森氏菌显色平板 |
90mm |
10个/包,2包/盒 |
|
CA243P-70 |
科玛嘉念珠+显色平板 |
70mm |
10个/包,2包/盒 |
|
CA243P-90 |
科玛嘉念珠+显色平板 |
90mm |
10个/包,2包/盒 |
|
SM302P-70 |
科玛嘉粘质沙雷氏jun显色平板 |
70mm |
10个/包,2包/盒 |
|
SM302P-90 |
科玛嘉粘质沙雷氏jun显色平板 |
90mm |
10个/包,2包/盒 |
|
SP372P-70 |
科玛嘉A族链球菌显色平板 |
70mm |
10个/包,2包/盒 |
|
SP372P-90 |
科玛嘉A族链球菌显色平板 |
90mm |
10个/包,2包/盒 |
|
CGRT2P-70 |
科玛嘉C3GR显色平板 |
70mm |
10个/包,2包/盒 |
|
CGRT2P-90 |
科玛嘉C3GR显色平板 |
90mm |
10个/包,2包/盒 |
|
EB042P-70 |
科玛嘉肠杆菌科细菌显色平板 |
70mm |
10个/包,2包/盒 |
|
EB042P-90 |
科玛嘉肠杆菌科细菌显色平板 |
90mm |
10个/包,2包/盒 |
|
CQ382P-70 |
科玛嘉葡萄球菌显色平板 |
70mm |
10个/包,2包/盒 |
|
CQ382P-90 |
科玛嘉葡萄球菌显色平板 |
90mm |
10个/包,2包/盒 |
|
CQ392P-70 |
科玛嘉链球菌显色平板 |
70mm |
10个/包,2包/盒 |
|
CQ392P-90 |
科玛嘉链球菌显色平板 |
90mm |
10个/包,2包/盒 |
|
LK970P-70 |
科玛嘉鉴定李斯特菌显色平板 |
70mm |
10个/包,2包/盒 |
|
LK970P-90 |
科玛嘉鉴定李斯特菌显色平板 |
90mm |
10个/包,2包/盒 |
|
MH482P-70 |
科玛嘉MH尿路菌群定位显色平板 |
70mm |
10个/包,2包/盒 |
|
MH482P-90 |
科玛嘉MH尿路菌群定位显色平板 |
90mm |
10个/包,2包/盒 |
|
CO262P-70 |
科玛嘉COL-APSE 显色平板 |
70mm |
10个/包,2包/盒 |
|
CO262P-90 |
科玛嘉COL-APSE 显色平板 |
90mm |
10个/包,2包/盒 |
|
TX182P-70 |
科玛嘉TBX显色平板 |
70mm |
10个/包,2包/盒 |
|
TX182P-90 |
科玛嘉TBX显色平板 |
90mm |
10个/包,2包/盒 |
|
EF342P-70 |
科玛嘉CCA显色平板 |
70mm |
10个/包,2包/盒 |
|
EF342P-90 |
科玛嘉CCA显色平板 |
90mm |
10个/包,2包/盒 |
风险提示:丁香通仅作为第三方平台,为商家信息发布提供平台空间。用户咨询产品时请注意保护个人信息及财产安全,合理判断,谨慎选购商品,商家和用户对交易行为负责。对于医疗器械类产品,请先查证核实企业经营资质和医疗器械产品注册证情况。
技术资料暂无技术资料 索取技术资料